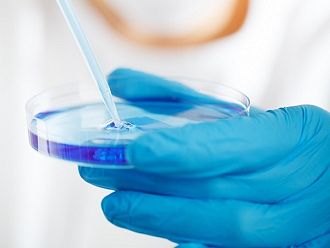
Експерти: Бъдещето на онкологичното лечение е в онколитичната вирусна терапия

"Последните 20-30 години онкологията е в своя възход и целта е персонализирана и прецизна онкология за всички пациенти спрямо биологичния характер на определения тумор“. Това каза в подкаста на БНР "В центъра на системата" онкоимунологът от Клиниката по медицинска онкология на УМБАЛ "Царица Йоанна“ – ИСУЛ д-р Георги Димитров.
По думите му до скоро основният метод за системно лечение е бил химиотерапията, като в някои случаи и сега тя е най-ефективният метод. „Целта й е да унищожи бързоделящи се клетки, каквито са туморните клетки, но тя не щади и нормалните клетки, които се делят бързо. Затова се наблюдават страничните ефекти при химиотерапията – повръщане, разстройство и косопад. В последните години обаче се работи с прицелно лечение, с имунотерапия, с комбинацията между двете и комбинацията и с химиотерапията, и може би най-новата вълна - т.нар. конюгантни медикаменти. Това са антитела, с прикрепени към тях няколко молекули химиотерапевтик, което прави доставянето на този химиотерапевтик още по-прецизно. Той влиза основно в туморната клетка, с много малко, което отива в страничната тъкан и страничните ефекти са много малко“, поясни д-р Димитров.
Инфекционистът от Инфекциозна болница в София и Катедра по инфекциозни болести към МУ София д-р Трифон Вълков подчерта, че тъй като не е онколог, не може да опише тенденциите, свързани с разработването на нови стратегии по отношение диагностика и терапия на злокачествените заболявания. „Когато обаче говорим за новости и за търсения в тази насока, няма как да не отбележим нещо, което е известно на науката - това е възможността за използването на вируси не само за терапия, но и за диагностика на злокачествените заболявания. Нещо повече - между самите онколози вече се говори за отделен стълб, свързан с терапията на онкологичните заболявания чрез вируси. Комбинирането на няколко фундаментални науки - генетика, вирусология и генното инженерство, даде възможност на вируси, познати на човечеството отдавна, по такъв начин да бъдат модифицирани, че да загубят своите патогенни свойства върху нашия организъм и таргетно да атакуват този тип клетки, които са в основата на туморното заболяване, самата туморна тъкан. Това е пример за таргетна терапия“, каза той.
Според д-р Вълков таргетът може да бъде постигнат не само с вирусни клетки, но и с антитела, които също са пример за такъв тип терапия. „Това, което отличава вирусите като патогенна частица е именно способността да разпознават отделни клетки в състава на една и съща тъкан. Те се разделят най-общо на три големи групи - това са т. нар. онколитични вируси, немодифицирани, които по принцип притежават възможността, такъв ефект упражняват - атакувайки съответната тъкан, да предизвикат лизис - разрушаване на клетката, в която навлязат. Вирусите, които се използват в тази насока са херпесната група вируси, морбили, грип, аденовируси, още други, които са в стадий на доразработване и изследване“, каза той.
Д-р Димитров уточни, че прицелното лечение се прилага вече рутинно, то се оптимизира и развива. „Това, за което доц. Вълков говори - онколитичната вирусна терапия - тя предстои тепърва. Това е бъдещото на онкологичното лечение. С тези три стълба на този вид лечение - директния и индиректния начин за унищожаване на тумора. Тоест - дали вирусът ще може да се размножава само в определените туморни клетки - модифицирани или с естествен вид. Ние знаем кои вируси имат тропизъм към кои определени туморни клетки - при рака на гърдата и при рака на маточната шийка са различни. Различни вируси имат тропизъм към точно тези различни локализации. Другото нещо е индиректният начин - дали чрез разкриване на антигени, които имунната система не ги е виждала първоначално или чрез модифициране на туморната микросреда. Която е в момента много актуална тема за "разузнаване", чрез различни механизми, включително и чрез промяна микробиома на тумора, защото епителните тумори, карциномите, които произлизат от кухи органи, примерно на червата, на дихателните пътища, като рака на белия дроб, имат микросреда, която те развиват като микроорганизми. Промяната на това може да доведе до съвсем различно поведение на тумора и съвсем различно поведение на имунната система спрямо тумора. Онколитичната вирусна терапия може да промени и да направи този тумор видим. Хитът, който имунотерапията от последните може би 10 години, още от меланома, всички сте чували за т.нар. инхибитори на имунната контролна точка - това е когато, туморите резистират имунния отговор. Тоест те го спират чрез "едни спирачки" да разпознават имунните клетки и да ги толерират. Ние като лекари онколози имаме възможност да дадем антитела, които "стопират тези спирачки", махат ги и имунната система почва да ги вижда. Обаче не винаги е така, не във всеки тумор и не може да предскажем със сигурност кой тумор ще реагира напълно към имунотерапията и какъв ще е отговорът.
Добавяйки и онколитичната вирусна терапия, поне теоретично към момента вървят проучвания, още са с междинни, но обещаващи резултатите, може да допълним този отговор и да постигнем изцяло унищожаване на тумори само със системно лечение, изтъква д-р Георги Димитров.
Според д-р Вълков няма тъкан, която да не може да се изроди в ракова и няма тъкан, към която не може да се насочат конкретни вируси. „Тоест срещу всеки вид тумор може да бъде създаден модифициран вирус“, каза той.
Експертите обаче уточниха, че засега онколитичната терапия може да се прилага само локално - при директно инжектиране в тумора.
Целия епизод на подкаста може да чуете тук.
Коментари по темата
Явно предстои да се обособи нова специалност - онкоинфекционист - след като вече и инфекционистите започнаха да се пробват на онкологичния терен. И това е разбираемо, онкологията е новата златна мина в медицината. За това говорят нагласените поръчки за онкологични лекарства (нали, д-р Ани Петрова?) и разкриването на десетки онкологични отделения под път и над път, без видим терапевтичен резултат в национален план. А за ИСУЛ - просто огледайте автопарка на болницата и ще видите как захлебват докторчетата там.